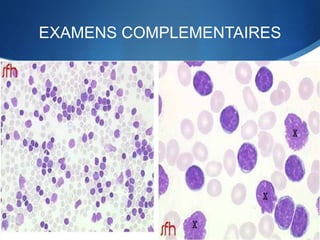
EXAMENS COMPLEMENTAIRES
a) Hémogramme :
-Hyperleucocytose 50 000 a 100 000 GB/mm3
avec hyperlymphocytose sanguine
-Anémie , Thrombopénie
b) Frottis sanguin :proliferation cellulaire
monomorphe faite de petits lymphocytes proche
du lymphocyte normal ,avec presence d’ombre de
Gumprecht

La leucémie lymphoïde chronique (LLC) est une prolifération lymphoïde monoclonale touchant principalement les personnes âgées, avec des symptômes tels que l'hyperleucocytose et des adénopathies. Le diagnostic repose sur l'immunophénotypage et des examens hématologiques, tandis que le traitement comprend une chimiothérapie et parfois une greffe de moelle osseuse. Les complications peuvent inclure des infections, des anémies et une transformation en lymphome agressif.